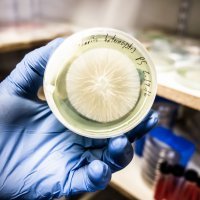
DSCF5172

MAKE Magazine and Instructables.com's Blog, page 420
August 5, 2016
This Retro Futuristic Ray Gun Is Upcycled and Awesome
 No self-respecting interplanetary home owner would be caught without this ray gun stowed in their rocket ship.
No self-respecting interplanetary home owner would be caught without this ray gun stowed in their rocket ship.
The post This Retro Futuristic Ray Gun Is Upcycled and Awesome appeared first on Make: DIY Projects and Ideas for Makers.
Maker Spotlight: E. Rega
 Where's the line between clothing and costume? E. Rega dances over the line with their playful sewing projects.
Where's the line between clothing and costume? E. Rega dances over the line with their playful sewing projects.
The post Maker Spotlight: E. Rega appeared first on Make: DIY Projects and Ideas for Makers.
August 4, 2016
Denville New Jersey’s Maker Camp is Rocking It
 Christine Lupia-Fugere shares her inspiring Maker Camp experience! (Hint: it's fantastic.)
Christine Lupia-Fugere shares her inspiring Maker Camp experience! (Hint: it's fantastic.)
The post Denville New Jersey’s Maker Camp is Rocking It appeared first on Make: DIY Projects and Ideas for Makers.
5 Fantastic Sharpening Tips and Techniques
 Always keep your edge, with these five tool sharpening tutorials.
Always keep your edge, with these five tool sharpening tutorials.
The post 5 Fantastic Sharpening Tips and Techniques appeared first on Make: DIY Projects and Ideas for Makers.
Cucumber Machines, Adorable Felt Plushies, and More at Maker Faire Tokyo
 Every year Maker Faire Tokyo impresses with the sheer number of cool things to see. If you can make it this weekend, go!
Every year Maker Faire Tokyo impresses with the sheer number of cool things to see. If you can make it this weekend, go!
The post Cucumber Machines, Adorable Felt Plushies, and More at Maker Faire Tokyo appeared first on Make: DIY Projects and Ideas for Makers.
From the US Industrial Revolution to a Mini Maker Faire
 Rhode Island: home to a thriving community of Makers. This weekend they'll gather at the Rhode Island Mini Maker Faire.
Rhode Island: home to a thriving community of Makers. This weekend they'll gather at the Rhode Island Mini Maker Faire.
The post From the US Industrial Revolution to a Mini Maker Faire appeared first on Make: DIY Projects and Ideas for Makers.
Bill Domby’s Metalwork Menagerie
 Bill left a legacy in the form of a metal sculpture zoo featuring elephants, bears, toads, and more (much more).
Bill left a legacy in the form of a metal sculpture zoo featuring elephants, bears, toads, and more (much more).
The post Bill Domby’s Metalwork Menagerie appeared first on Make: DIY Projects and Ideas for Makers.
Get to Know Biohacking Safari
A biohacker is someone with the mindset of a hacker, but who works with different tools, such as pipettes, incubators, tubes or petrie dishes.
A biohacker is someone with the mindset of a hacker, but who works with different tools, such as pipettes, incubators, tubes or petrie dishes.
The post Get to Know Biohacking Safari appeared first on Make: DIY Projects and Ideas for Makers.
Upgrading a Basic Shed into a Solar-Powered Workshop
 This refurbished shed is completely off-the-grid thanks to a solar power upgrade. Besides power, it also now has AC!
This refurbished shed is completely off-the-grid thanks to a solar power upgrade. Besides power, it also now has AC!
The post Upgrading a Basic Shed into a Solar-Powered Workshop appeared first on Make: DIY Projects and Ideas for Makers.
Maker Spotlight: Balam Soto
 Balam is a New Media Artist who creates incredible artistic installations that feature interactivity and a fusion of high and low tech, fueled by his custom hardware and software.
Balam is a New Media Artist who creates incredible artistic installations that feature interactivity and a fusion of high and low tech, fueled by his custom hardware and software.
The post Maker Spotlight: Balam Soto appeared first on Make: DIY Projects and Ideas for Makers.
MAKE Magazine and Instructables.com's Blog



